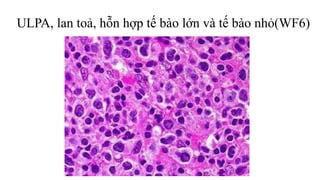
ULPA, lan toả, hỗn hợp tế bào lớn và tế bào nhỏ(WF6)
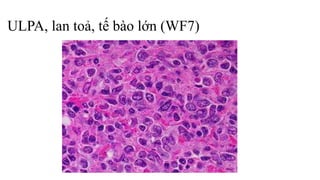
ULPA, lan toả, tế bào lớn (WF7)

Tài liệu trình bày về bệnh học của hạch bạch huyết, bao gồm cấu trúc và chức năng của hệ bạch huyết cũng như phân loại các bệnh như viêm, quá sản và ung thư hạch. Đặc điểm vi thể của các loại u lympho, đặc biệt là bệnh Hodgkin và không Hodgkin, được mô tả chi tiết cùng với cách phân loại và tiên lượng. Nghiên cứu còn đề cập đến các triệu chứng lâm sàng và sự phát triển của bệnh trong các giai đoạn khác nhau.